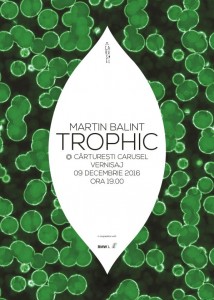
P90244453_lowRes_trophic-art-installa

Din 9 decembrie, o nouă instalație artistică va atrage privirile cititorilor din Cărturești Carusel. Suspendată în spațiul central al librăriei, TROPHIC este creația artistului vizual Martin Balint și le propune vizitatorilor un joc de perspective asupra echilibrului în natură, oscilând între micro și macro, vizibil și imperceptibil.
Din 9 decembrie, o nouă instalație artistică va atrage privirile cititorilor din Cărturești Carusel. Suspendată în spațiul central al librăriei, TROPHIC este creația artistului vizual Martin Balint și le propune vizitatorilor un joc de perspective asupra echilibrului în natură, oscilând între micro și macro, vizibil și imperceptibil.
Proiectul – susținut de Cărturești în parteneriat cu BMW i România – își propune să aducă artiștii români contemporani mai aproape de public prin expunerea lucrărilor acestora într-un spațiu alternativ, ușor accesibile comunității, precum cel din centrul librăriei Carusel. Proiectul face parte dintr-un program mai amplu al librăriilor Cărturești, care pune în legătură artiști contemporani și branduri interesate de zona artei și a industriilor creative din România.
TROPHIC poate fi vizitat în Carusel până în 9 februarie 2017.
Prin expunerea unei frunze formate din 2443 de sfere interconectate, reprezentând celulele unei structuri vegetale, TROPHIC își asumă rolul de a reda emoția conceptului de natură cu toată complexitatea acesteia. Frunza este supradimensionată într-o asemena măsură încât se poate observa structura celulară cu ochiul liber sau cel puțin interpretarea unei structuri celulare atât de nesemnificativă pentru comunicarea simbolului în sine, dar vitală pentru existența biologică.
În spatele acestei forme sculpturale hiperbolizate, Martin Balint ascunde intenționat principiile ecologiei, cu structura ecosistemelor în cadrul cărora are loc un permanent transfer de energie şi materie, pentru ca viața să-și poată păstra caracteristica ciclică. Această legătură energetico-materială dintre diferitele specii ale unei bioceneze, în care unele au rolul de producători de energie (plantele), iar altele de consumatori este definită în biologie ca lanţ trofic. De aici și titlul lucrării, care prezintă primul nivel trofic dintr-un astfel de lanț care are ca scop principal de a întreține viața și echilibrul în natură.
„Librăria Cărtureşti Carusel este unul din reperele Bucureştiului. Suntem încântaţi că putem să fim alături de acest spaţiu emblematic susţinând un proiect cultural, o instalaţie de artă. TROPHIC este un proiect care vorbeşte despre nautră şi legăturile energetice din ecosisteme, despre echilibrul din natură, concepte care se identifică cu preocuparea BMW i pentru dezvoltare durabilă”, a explicat Dana Popescu, brand manager BMW i România, citata de autostiri.ro.
Martin-Emilian Balint trăiește și lucrează în București. Din 2004 este Creative Director al agenției HIPPOS. A absolvit Academia de Artă din Veneţia fiind specializat în noi tehnologii în artă și istoria artei contemporane. Este unul dintre fondatorii colectivului artistic internațional CREAM (Creativity and Research in Arts and Media) și are în portofoliu expoziții internaționale precum Miniartextil în Paris și Como, Bride în Larnaka Cipru, Crossbreeds în Viena.
Sursa: comunicat remis Autostiri.ro




